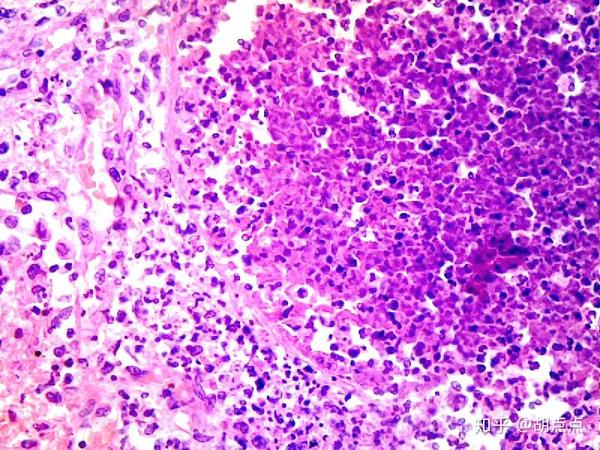
急性肺瘀血慢性肺瘀血蜂窝织性阑尾炎肺脓肿鳞状上皮细胞乳头状瘤电镜

肺脓肿显微镜图片

化脓性肺炎400
图片尺寸960x1280
病理学切片 肺脓肿
图片尺寸1152x720
肺炎的脓肿灶高倍镜
图片尺寸504x331
老年人肺脓肿
图片尺寸300x225
图a显示多灶性脓肿形成.
图片尺寸1500x1707
化脓性肺炎3(10x40)
图片尺寸500x375
【临床精粹】肺炎系列28-吸入性肺脓肿
图片尺寸1024x768
【临床精粹】肺炎系列28-吸入性肺脓肿
图片尺寸1280x960
4急性蜂窝织性阑尾炎 p5肺脓肿
图片尺寸962x1280
脓肿
图片尺寸1080x810
念珠菌感染所致的肺脓肿镜下
图片尺寸504x332
高等学校病理玻片标本 人肺气肿切片 呼吸系统 显微镜生物切片
图片尺寸750x750
肺脓肿,脓液穿刺图片
图片尺寸311x270
肺脓肿的病理标本图例 肺脓肿的病理切片显微镜图例
图片尺寸559x198
6.肺脓肿:局限性中性粒细胞浸润.箭头标记处为脓肿.5.
图片尺寸504x330
图片浏览
图片尺寸300x223
1例小细胞肺癌误诊为肺脓肿诊治分析
图片尺寸399x440
急性肺瘀血,慢性肺瘀血,蜂窝织性阑尾炎,肺脓肿,鳞状上皮细胞乳头状瘤
图片尺寸800x600
急性肺瘀血慢性肺瘀血蜂窝织性阑尾炎肺脓肿鳞状上皮细胞乳头状瘤电镜
图片尺寸720x540
急性肺瘀血慢性肺瘀血蜂窝织性阑尾炎肺脓肿鳞状上皮细胞乳头状瘤电镜
图片尺寸720x540